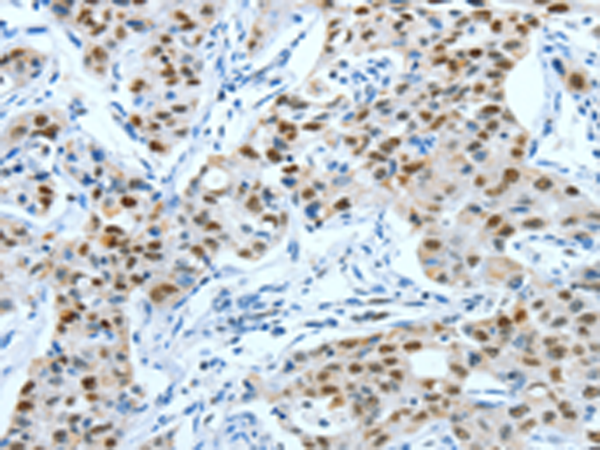
一抗

宿 主: Rabbit
克隆類型: rabbit polyclonal
技術規格
|
Background: |
This gene is the putative transforming gene of avian sarcoma virus 17. It encodes a protein which is highly similar to the viral protein, and which interacts directly with specific target DNA sequences to regulate gene expression. This gene is intronless and is mapped to 1p32-p31, a chromosomal region involved in both translocations and deletions in human malignancies. |
|
Applications: |
ELISA, IHC |
|
Name of antibody: |
JUN |
|
Immunogen: |
Fusion protein of human JUN |
|
Full name: |
jun proto-oncogene |
|
Synonyms: |
AP1; AP-1; c-Jun |
|
SwissProt: |
P05412 |
|
ELISA Recommended dilution: |
2000-5000 |
|
IHC positive control: |
Human lung cancer and Human colon cancer |
|
IHC Recommend dilution: |
25-100 |



 購物車
購物車 幫助
幫助
 021-54845833/15800441009
021-54845833/15800441009